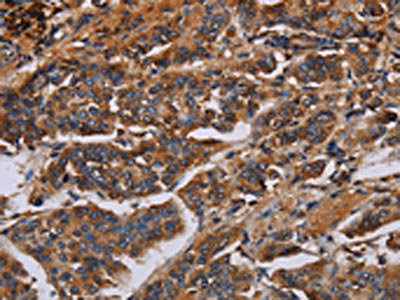

KCNQ1 Antibody
-
中文名稱:KCNQ1兔多克隆抗體
-
貨號(hào):CSB-PA942745
-
規(guī)格:¥1100
-
圖片:
-
The image on the left is immunohistochemistry of paraffin-embedded Human breast cancer tissue using CSB-PA942745(KCNQ1 Antibody) at dilution 1/50, on the right is treated with fusion protein. (Original magnification: ×200)
-
Gel: 8%SDS-PAGE, Lysate: 40 μg, Lane: Mouse heart tissue, Primary antibody: CSB-PA942745(KCNQ1 Antibody) at dilution 1/200, Secondary antibody: Goat anti rabbit IgG at 1/8000 dilution, Exposure time: 5 minutes
-
-
其他:
產(chǎn)品詳情
-
Uniprot No.:
-
基因名:
-
別名:KCNQ1; KCNA8; KCNA9; KVLQT1; Potassium voltage-gated channel subfamily KQT member 1; IKs producing slow voltage-gated potassium channel subunit alpha KvLQT1; KQT-like 1; Voltage-gated potassium channel subunit Kv7.1
-
宿主:Rabbit
-
反應(yīng)種屬:Human,Mouse,Rat
-
免疫原:Fusion protein of Human KCNQ1
-
免疫原種屬:Homo sapiens (Human)
-
標(biāo)記方式:Non-conjugated
-
抗體亞型:IgG
-
純化方式:Antigen affinity purification
-
濃度:It differs from different batches. Please contact us to confirm it.
-
保存緩沖液:-20°C, pH7.4 PBS, 0.05% NaN3, 40% Glycerol
-
產(chǎn)品提供形式:Liquid
-
應(yīng)用范圍:ELISA,WB,IHC
-
推薦稀釋比:
Application Recommended Dilution ELISA 1:1000-1:2000 WB 1:200-1:1000 IHC 1:50-1:200 -
Protocols:
-
儲(chǔ)存條件:Upon receipt, store at -20°C or -80°C. Avoid repeated freeze.
-
貨期:Basically, we can dispatch the products out in 1-3 working days after receiving your orders. Delivery time maybe differs from different purchasing way or location, please kindly consult your local distributors for specific delivery time.
-
用途:For Research Use Only. Not for use in diagnostic or therapeutic procedures.
相關(guān)產(chǎn)品
靶點(diǎn)詳情
-
功能:Potassium channel that plays an important role in a number of tissues, including heart, inner ear, stomach and colon. Associates with KCNE beta subunits that modulates current kinetics. Induces a voltage-dependent current by rapidly activating and slowly deactivating potassium-selective outward current. Promotes also a delayed voltage activated potassium current showing outward rectification characteristic. During beta-adrenergic receptor stimulation participates in cardiac repolarization by associating with KCNE1 to form the I(Ks) cardiac potassium current that increases the amplitude and slows down the activation kinetics of outward potassium current I(Ks). Muscarinic agonist oxotremorine-M strongly suppresses KCNQ1/KCNE1 current. When associated with KCNE3, forms the potassium channel that is important for cyclic AMP-stimulated intestinal secretion of chloride ions. This interaction with KCNE3 is reduced by 17beta-estradiol, resulting in the reduction of currents. During conditions of increased substrate load, maintains the driving force for proximal tubular and intestinal sodium ions absorption, gastric acid secretion, and cAMP-induced jejunal chloride ions secretion. Allows the provision of potassium ions to the luminal membrane of the secretory canaliculus in the resting state as well as during stimulated acid secretion. When associated with KCNE2, forms a heterooligomer complex leading to currents with an apparently instantaneous activation, a rapid deactivation process and a linear current-voltage relationship and decreases the amplitude of the outward current. When associated with KCNE4, inhibits voltage-gated potassium channel activity. When associated with KCNE5, this complex only conducts current upon strong and continued depolarization. Also forms a heterotetramer with KCNQ5; has a voltage-gated potassium channel activity. Binds with phosphatidylinositol 4,5-bisphosphate.; Non-functional alone but modulatory when coexpressed with the full-length isoform 1.
-
基因功能參考文獻(xiàn):
- Two voltage-gated K+ channel KCNQ1 (KCNQ1) gain-of-function mutations that cause a genetic form of atrial fibrillation, S140G and V141M, drastically slow IKs deactivation. PMID: 28383569
- There was no significant difference in current density between heterozygous KCNQ1-F127L, -P477L, or -L619M variant-containing channels compared to KCNQ1-WT. PMID: 29197658
- inactivation of KCNQ1 channels derives from the different mechanisms of the voltage sensor domain-pore coupling that lead to the intermediate open (IO) and activated open (AO) states PMID: 29167462
- Results reveal a role for the KCNQ1 potassium channel in the regulation of growth, and show that growth hormone deficiency associated with maternally inherited gingival fibromatosis is an allelic disorder with cardiac arrhythmia syndromes caused by KCNQ1 mutations. PMID: 29097701
- The conservation of homologous residues in helix B of other Kv7 subtypes confer similar competition of Ca(2+)-calmodulin (CaM) with PIP2 binding to their proximal C-termini and suggest that PIP2-CaM interactions converge to Kv7 helix B to modulates channel activity in a Kv7 subtype-dependent manner. PMID: 28976808
- expression of the nearby cyclindependent kinase inhibitor 1C (CDKN1C) gene was revealed to be upregulated after SP3 knockdown in cells that possessed non-risk alleles. This suggests that CDKN1C is potentially one of the functional targets of SNP rs163184, which modulates the binding activity of the locus for Sp3 and Lsd1/Kdm1a PMID: 29207083
- Electron Microscopy of Full-Length alpha-Subunit of Human Potassium Channel Kv7.1 PMID: 29738690
- Predicting the Functional Impact of KCNQ1 Variants of Unknown Significance PMID: 29021305
- Low KCNQ1 expression is associated with colorectal cancer. PMID: 28373572
- these data strongly suggest that KCNQ1 genetic polymorphism influences repaglinide response due to the pivotal role of KCNQ1 in regulating insulin resistance through the IRS-2/PI(3)K/Akt signaling pathway. PMID: 27857189
- Residues K526 and K527 in Kv7.1 helix B form a critical site where CaM competes with PIP2 to stabilize the channel open state. The LQT mutant K526E revealed a severely impaired channel function with a right shift in the voltage dependence of activation, a reduced current density, and insensitivity to gating modulation by Ca(2+)-CaM. PMID: 28096388
- data identify D242 aminoacidic position as a potential residue involved in the KCNE1-mediated regulation of the voltage dependence of activation of the KV7.1 channel. PMID: 28739325
- findings presented here will have some implications in understanding the potential off-target interactions of the drugs with the KCNQ1/KCNE1 channel that lead to cardiotoxic effects PMID: 29444113
- The occurrence of KCNQ1 gene mutations in patients after MI is higher in men than in women. The presence of KCNQ1 gene mutations is not an additional risk factor for increased mortality in patients after MI. PMID: 29064790
- The first evidence that synonymous variants outside the canonical splice sites in KCNQ1 can alter splicing and clinically impact phenotype. PMID: 28264985
- changes in methylation rates in umbilical cord samples were associated with the proportion of Firmicutes in the maternal gut PMID: 27863092
- Novel Single Nucleotide Polymorphism at KCNQ1 implicate gene regulatory dysfunction in QT prolongation in African and Hispanic Americans. PMID: 27988371
- We investigated the modification of air pollution and diabetes association by a genetic risk score covering 63 T2D genes. Five single variants near GRB14, UBE2E2, PTPRD, VPS26A and KCNQ1 showed nominally significant interactions with PM10 (P<0.05). Our results suggest that genetic risk for T2D may modify susceptibility to air pollution through alterations in insulin sensitivity. PMID: 27281273
- Structural, computational, biochemical, and electrophysiological studies lead to an atomically explicit integrative structural model of the KCNE3-KCNQ1 complex that explains how KCNE3 induces the constitutive activation of KCNQ1 channel activity, a crucial component in K(+) recycling. PMID: 27626070
- in patients with type 2 diabetes, KCNQ1 rs163184 T>G variant was associated with a reduced glycaemic response to dipeptidylpeptidase-4 inhibitors( DPP4I) PMID: 28624668
- A small subgroup of patients with mutations on both KCNQ1 alleles and prolonged QT intervals do not present with Deafness but appear to have a similar risk of cardiac events as Jervell and Lange-Nielsen syndrome patients. PMID: 27451284
- 3' Untranslated region SNPs are not acting as genetic modifiers in a large group of LQT1 patients. PMID: 27531917
- This study presents biallelic gene mutations in KCNQ1 in Asian Indian patients with AR JLNS and RWS. It adds to the scant worldwide literature of mutation studies in AR RWS. PMID: 27041150
- The KCNQ1 gene has been also associated with Dilated cardiomyopathy in patients carrying a genetic variant that provokes a loss of function of potassium cannel or auto-immune deficiency. PMID: 27736720
- rs8234, in the KCNQ1 3' untranslated region was associated with joint processing speed and white matter impairments in schizophrenia. PMID: 28188958
- DNA methylation of KCNQ1 is likely to be on the causal pathway for type 2 diabetes in later life. PMID: 28246294
- GWAS identified two known loci (TCF7L2 and KCNQ1) reaching genome-wide significance levels in Hispanic type 2 diabetes patients. Conditional analysis on known index single nucleotide polymorphisms (SNPs) indicated an additional independent signal at KCNQ1, represented by an African ancestry-specific variant, rs1049549. PMID: 28254843
- Long QT syndrome causing alleles of maternal origin are more frequent than of paternal origin. PMID: 26669661
- Kv7.1 and its isoforms are regulated by both PIP2 and polyunsaturated fatty acids and play a variety of important roles in human health and in heart, neural and other diseases. (Review) PMID: 27818172
- Compound mutations of KCNQ1 were found to be the etiology of Jervell and Lange-Nielsen Syndromeof in four patients from three Chinese families. PMID: 27809696
- conclude that KCNQ1 is a promising biomarker for prediction of disease recurrence and may aid stratification of patients with stage II MSS colon cancer for adjuvant chemotherapy PMID: 27855440
- present genetic and phenotypic data for 4 family members across 2 generations who all have evidence of prolonged QT interval and left ventricular noncompaction in association with a pathogenic mutation in KCNQ1, and discuss the potential mechanisms of this association PMID: 28249770
- Study provides evidence that SNPs of JMJD1C and KCNQ1 are prospectively associated with the risk of type 2 diabetes (T2D) in Korean population. Additionally, CDKAL1 may not be associated with T2D onset over the age of 40. PMID: 28406950
- c.1025T>C and c.1011C>G associated with long QT syndrome PMID: 28003625
- Chinese family with dual LQT1 and HCM phenotypes associated with tetrad heterozygous mutations in KCNQ1, MYH7, MYLK2, and TMEM70 mutations. PMID: 25825456
- the rs2237892 SNP in KCNQ1 may be a susceptible locus for T2DM in female Kazakh individuals. Furthermore, CT/TT are susceptible genotypes and T is a susceptible allele at this locus. However, the KCNQ1 rs2237895 SNP does not appear to be associated with T2DM in the Chinese Kazakh population. PMID: 27323013
- After adjustment for age, sex, and BMI, rs163182 in KCNQ1 and rs7612463 in UBE2E2 were found to be associated with Type 2 Diabetes Mellitus risk in Chinese Han population. PMID: 27175665
- 176 cases of drowning were screened for mutations in the exons 3, 5, 6, 7, and 8 of the KCNQ1; no variation to the published sequence could be found in the exonic DNA in any of the cases clearly disproving an involvement of these mutation clusters in cases of drowning PMID: 26370830
- Mutation W305L in the P-loop domain of the Kv7.1 may derive a pronounced benefit from beta-blocker therapy in symptomatic long QT syndrome patients, whereas mutation R380S located in the C-terminus may be associated with a high risk of sudden cardiac death PMID: 26344792
- results suggest that a common KCNQ1 intron 12 indel polymorphism is a risk factor for impaired renal function independent of type 2 diabetes PMID: 26970180
- After adjustment for sex, gestational weeks, parity, and maternal age, alleles of KCNQ1 were associated with higher birth weight and increased risk of impaired glucose metabolism. PMID: 26109524
- KCNQ1 is associated with an increased risk for T2 diabetes mellitus(T2DM) and might contribute to the higher incidence of hypertension and macrovascular complications in patients with T2DM carrying the risk allele C. PMID: 26678516
- Stop-codon mutations are associated with a lower risk of cardiac events in patients with QT syndrome type 1, while frameshift mutations are associated with the same risk as the majority of the missense mutations. PMID: 26318259
- a novel association between rs2283171 of KCNQ1 and T2D in the Uyghur population. PMID: 26540651
- After screening, we identified G643S as a putative causative heterozygous mutation in the KCNQ1 gene. This mutation has been reported in abnormalities consistent with sudden unexplained death syndrome. PMID: 26385840
- Data show that voltage-gated potassium channel KCNE3 directly affects the S4 movement in potassium channel KCNQ1. PMID: 26668384
- KCNQ1/KCNE3 channels make only a small contribution to basolateral conductance in normal colonic crypts, with increased channel activity in UC appearing insufficient to prevent colonic cell depolarization in this disease. PMID: 26718405
- This study showed that KCNQ1 methylation was associated with insulin resistance after weight loss intervention program in obese stroke. PMID: 26238466
- Calml3 may be a constituent of epithelial KCNQ1 channels and underscores the molecular diversity of endogenous KCNQ1 channels PMID: 26184980
- A novel KCNQ1-G229D mutation identified in a juvenile-onset AF patient altered the IKs activity and kinetics, thereby increasing the arrhythmogenicity to AF. PMID: 24096004
顯示更多
收起更多
-
相關(guān)疾病:Long QT syndrome 1 (LQT1); Jervell and Lange-Nielsen syndrome 1 (JLNS1); Atrial fibrillation, familial, 3 (ATFB3); Short QT syndrome 2 (SQT2); Diabetes mellitus, non-insulin-dependent (NIDDM)
-
亞細(xì)胞定位:Cell membrane; Multi-pass membrane protein. Cytoplasmic vesicle membrane. Early endosome. Membrane raft. Endoplasmic reticulum. Basolateral cell membrane.
-
蛋白家族:Potassium channel family, KQT (TC 1.A.1.15) subfamily, Kv7.1/KCNQ1 sub-subfamily
-
組織特異性:Abundantly expressed in heart, pancreas, prostate, kidney, small intestine and peripheral blood leukocytes. Less abundant in placenta, lung, spleen, colon, thymus, testis and ovaries.
-
數(shù)據(jù)庫(kù)鏈接:
Most popular with customers
-
-
YWHAB Recombinant Monoclonal Antibody
Applications: ELISA, WB, IHC, IF, FC
Species Reactivity: Human, Mouse, Rat
-
Phospho-YAP1 (S127) Recombinant Monoclonal Antibody
Applications: ELISA, WB, IHC
Species Reactivity: Human
-
-
-
-
-